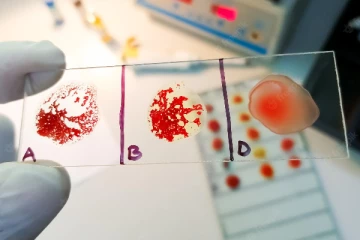
தங்க ரத்தம்…மனிதர்களுக்கு இருக்கும் மிக அரிய ரத்தத்தில் இவ்வளவு சிறப்பா?

நயன்தாராவின் குழந்தைகளுக்கு வாடகைத் தாய் யார் தெரியுமா? இருவருக்கும் இப்படி ஒரு உறவா? 3 ஆண்டுகள் முன்

3வது நாளாக கடும் வீழ்ச்சியில் தங்கம் விலை! இன்னும் விலை குறையுமா? வல்லுநர்களின் குட்நியூஸ் 3 ஆண்டுகள் முன்

புதிய காருடன் ரசிகர்களுக்கு இன்ப அதிர்ச்சி கொடுத்த பூவையார்! புகைப்படத்துடன் நெகிழ்ச்சி பதிவு 3 ஆண்டுகள் முன்

ஒரே நேரத்தில் நீரிழிவு நோய், ரத்த அழுத்தத்தை கட்டுப்படுத்தனுமா? இந்த ஒரு பானம் போதும் 3 ஆண்டுகள் முன்

ஹீரோயினாக மாறிய தாமரை! புதிய லுக்கில் எப்படி இருக்கின்றார் தெரியுமா? குவியும் வாழ்த்துக்கள் 3 ஆண்டுகள் முன்

இலங்கையர்கள் மகிழ்ச்சி... ஜனனியின் நட்பு தான் வேணும்! அடம் பிடித்த GP முத்து - தீயாய் பரவும் வீடியோ 3 ஆண்டுகள் முன்

சக்கரை நோயாளிகள் விரும்பி ருசிக்கும் கேழ்வரகு பூரி...10 நிமிடத்தில் செய்து அசத்தலாம்! 3 ஆண்டுகள் முன்

சூப்பர் சிங்கர் புகழ் பூவையாரா இது? 14 வயதில் விலையுயர்ந்த காருக்கு சொந்தகாரரானார்....இவ்வளவு வளர்ந்து விட்டாரா? 3 ஆண்டுகள் முன்

தீ வைத்தவர்கரள திரும்பித் தாக்கிய பலி வாங்கிய ராவணன்! அலறி ஓடிய கூட்டம்...கடும் பரபரப்பை ஏற்படுத்திய அதிர்ச்சி காட்சி 3 ஆண்டுகள் முன்
13ம் ஆண்டு நினைவஞ்சலி
2ம் ஆண்டு நினைவஞ்சலி
(+44) 20 3137 6284
UK
(+41) 315 282 633
Switzerland
(+1) 437 887 2534
Canada
(+33) 182 888 604
France
(+49) 231 2240 1053
Germany
(+1) 929 588 7806
US
(+61) 272 018 726
Australia
lankasri@lankasri.com
Email US